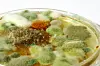

Muggsopp – lett å dyrke, krevende å tolke.
Foto: Mycoteam/Sveinung Bråthen
Fortsatt ledige plasser igjen på Nasjonalt fuktseminar
Fukt går aldri av moten, og et nytt fuktseminar står for døren. Ett av spørsmålene som tas opp på seminaret 13. april, er om vi faktisk må godta at det finnes fuktskader i bygninger
Denne artikkelen er over ti år gammel.
Det er nå allment kjent at fuktskader kan ha helsekonsekvenser, og at slike skader bør utbedres raskt og grundig. Analysemetodene blir stadig flere, og markedet for profesjonelle skadeundersøkelser ser ut til å være i vekst. Likevel kan det være uklart hvordan ulike prøveresultater skal tolkes. Når betyr et avvikende prøveresultat at man har en skade, og kan man egentlig regne med at et nybygg eller en eldre bolig er fri for skader?
Nasjonalt Fuktseminar er et årlig møtepunkt for forskere, rådgivere og praktikere som arbeider med forebygging, undersøkelse og utbedring av fuktskader. Onsdag 13. april er det klart for 2016-utgaven av arrangementet, og i år kan du få vite mer om hva man kan få ut av ulike prøveanalyser, hvordan fuktskader og prøvesvar vurderes fra et medisinsk og et juridisk synspunkt, og om regelverket sikrer at kjøperne av nye bygninger får skadefrie bygg.
13 foredragsholdere vil bidra til at dagen blir både lærerik og underholdende. I tillegg vil SINTEF Byggforsk presentere viktige forskningsrapporter og -publikasjoner fra 2015 og 2016.
Nasjonalt fuktseminar arrangeres av SINTEF Byggforsk og Mycoteam.
Les mer her